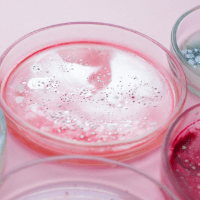

🚀 Curso EAD - Bacteriologia Aplicada à Biotecnologia - Certificado 120 horas incluso é Bom Mesmo? Descubra Agora!
👤 Autor: IPEDSS
💻 Plataforma: Eduzz
📦 Formato: 100% Digital
🔒 Garantia: 7 dias incondicional
📋 O que é o Curso EAD - Bacteriologia Aplicada à Biotecnologia - Certificado 120 horas incluso?
O curso avançado é oferecido pelo Instituto de Pesquisa e Determinação Social da Saúde – IPEDSS, através do programa ipedss academy na modalidade EAD. A dinâmica de ensino conta com um campus virtual moderno com aulas online, material de apoio, suporte especializado e certificação. Este Curso é supervisionado pela Dra. Andréa Vieira Colombo Doutorado em Ciências Biológicas (Microbiologia) Cont... saiba mais
🎯 Por que Vale a Pena?
- ✔️ Conteúdo digital acessível 24/7
- ✔️ Ideal para quem busca praticidade e liberdade
- ✔️ Compra segura via Eduzz com suporte profissional
- ✔️ Garantia de 7 dias — seu risco é zero!
É online, então não precisa esperar entrega! Acesso pela plataforma Eduzz 💡📱
Se não curtir, você pode solicitar reembolso em até 7 dias pela plataforma Eduzz. 💸👍